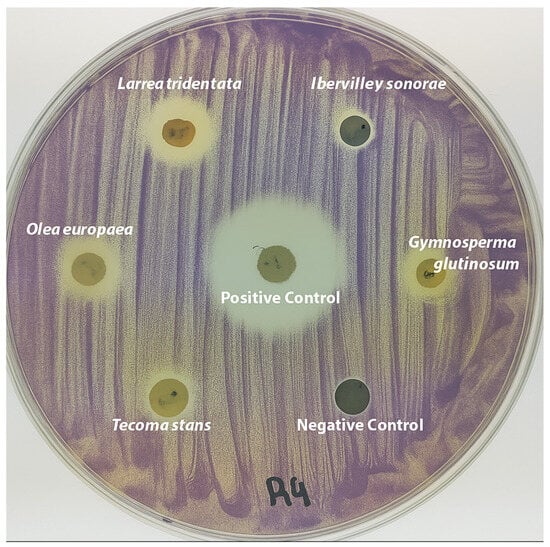

Abstract
The growing threat of antibiotic-resistant Gram-negative bacteria highlights the urgent need for innovative, non-bactericidal therapeutic strategies. Quorum-sensing (QS) inhibition has emerged as a promising approach to attenuate bacterial virulence without exerting selective pressure. This study evaluated the antimicrobial, anti-QS, and antibiofilm properties of aqueous extracts from five medicinal plants native to northeastern Mexico: Gymnosperma glutinosum, Ibervillea sonorae, Larrea tridentata, Olea europaea, and Tecoma stans. Disk diffusion and violacein quantification assays using Chromobacterium violaceum demonstrated significant QS inhibition by G. glutinosum and T. stans, with violacein reductions of 60.02% and 52.72%, respectively, at 40 mg/mL. While L. tridentata and O. europaea exhibited antibacterial activity, I. sonorae showed no growth or pigment inhibition but achieved the highest biofilm disruption (89.89%) against Salmonella typhimurium. UPLC-MS analysis identified chlorogenic acid, kaempferol, and D-(−)-quinic acid as major constituents, compounds previously associated with QS modulation. These findings highlight the potential of traditional Mexican plant species as sources of QS inhibitors and bio-film-disrupting agents, supporting their further development as alternatives to conventional antibiotics.
1. Introduction
The escalating crisis of antibiotic resistance represents one of the most urgent threats to global health today. Decades of antibiotic overuse and misuse have fueled the rise of multidrug-resistant bacterial strains, transforming once-treatable infections into formidable clinical challenges. This alarming trend is particularly severe within the agro-food chain, amplifying the risk of resistant pathogens entering human populations [1].
Recognizing the severity of the issue, the World Health Organization has identified twelve bacterial families as critical targets for new antimicrobial strategies [2]. Among them, Gram-negative pathogens such as Salmonella spp., Pseudomonas aeruginosa, and Staphylococcus aureus stand out due to their adaptive resistance mechanisms and dwindling treatment options. The urgent need for innovative, effective solutions has never been greater.
To tackle this challenge, a multipronged approach is essential—one that integrates rational antibiotic stewardship, the search for novel therapeutic agents, and preventative measures that reduce infection risks. Among emerging strategies, the targeting of bacterial quorum-sensing (QS) systems has garnered increasing attention. Rather than killing bacteria directly, QS inhibition disrupts bacterial communication, preventing the expression of virulence factors and biofilm formation and thereby reducing pathogenicity without imposing selective pressure for resistance [3,4,5]. QS is a density-dependent communication mechanism that regulates key bacterial behaviors, including motility, biofilm development, toxin production, and environmental adaptation [2]. Mediated predominantly by N-acyl homoserine lactones (AHLs) in Gram-negative bacteria, QS enables collective gene regulation once a critical population threshold is reached [6]. Disrupting this communication network offers a powerful, resistance-breaking antimicrobial strategy.
Mexico, a biodiversity hotspot with over 25,000 plant species [7], offers a largely untapped reservoir of potential antimicrobial agents. Previous studies have demonstrated the antimicrobial, antioxidant, and cytotoxic properties of Mexican medicinal plants, largely attributed to their rich secondary metabolite profiles [8,9,10,11]. Tecoma stans, for example, is rich in flavonoids such as chrysoeriol and other polyphenols [12], while Gymnosperma glutinosum contains diterpenes and long-chain alkanes with cytotoxic and antimicrobial activity [13].
However, the potential of these plants as sources of anti-quorum sensing (anti-QS) compounds remains underexplored. Notably, Larrea tridentata has been reported to produce various lignans and flavonoids with promising antibacterial properties [14], while extracts of Olea europaea have demonstrated antimicrobial activity attributed to their phenolic content [15]. Furthermore, some of these plants have also exhibited anti-parasitic potential, further broadening their therapeutic relevance beyond bacterial pathogens [16].
In this study, we investigated the antimicrobial, anti-QS, and anti-biofilm activities of aqueous extracts from five native medicinal plants of northeastern Mexico—Gymnosperma glutinosum, Ibervillea sonorae, Larrea tridentata, Olea europaea, and Tecoma stans—against Gram-negative bacteria. These species were selected based on their historical use in traditional medicine, documented safety, availability in arid and semi-arid regions of northeastern Mexico, and preliminary reports of biological activity. Importantly, the selection also sought to encompass chemical diversity, including species known to be rich in flavonoids, polyphenols, and other secondary metabolites associated with quorum-sensing inhibition. While some of these plants may exhibit high MIC values under standard in vitro conditions, their traditional efficacy is often attributed to the modulation of bacterial behavior, such as inhibition of adhesion, communication, or toxin production, rather than direct bactericidal activity. This distinction is particularly relevant in the context of quorum-sensing inhibition, which offers the possibility of attenuating pathogenicity without exerting selective pressure for resistance [17,18]. By exploring their phytochemical potential, we aim to uncover novel plant-derived agents capable of disarming bacterial pathogens and contributing to the global fight against antibiotic resistance.
2. Materials and Methods
2.1. Plant Material
Plant specimens were collected from the northeastern region of Mexico, specifically in General Escobedo, Nuevo León (25°48′30″ N, 100°19′36″ W). For precise botanical identification, voucher specimens were deposited in the herbarium of the Universidad Autónoma de Nuevo León, School of Biological Sciences.
Table 1 summarizes the botanical names, plant families, voucher codes, local and English common names, extracted plant parts, and aqueous extract yields. Collected plant material was dried and finely ground to ensure uniform extraction.

Table 1.
Botanical, taxonomic, and processing information of selected medicinal plants.
The selection of these five species Gymnosperma glutinosum, Ibervillea sonorae, Larrea tridentata, Olea europaea, and Tecoma stans was based on multiple criteria, including their extensive ethnomedicinal use in northern Mexico, documented biological activity, availability, and diversity in phytochemical composition [4,5,7,15,16,19]. Prior studies have reported that these plants are rich in flavonoids, organic acids, and other phenolics, compounds associated with antimicrobial and anti-inflammatory effects. Furthermore, they were selected not solely for their potential bactericidal properties, but also for their possible effects on bacterial virulence modulation, especially quorum-sensing inhibition. This mechanism is of relevance in the current context of antibiotic resistance, as it may suppress pathogenicity without exerting selective pressure for resistance. Thus, the chosen species represent promising candidates for identifying bioactive compounds that interfere with microbial communication and biofilm formation.
2.2. Bacterial Strains
The bacterial strains used in this study included Salmonella enterica serovar Typhimurium ATCC 14,028, Chromobacterium violaceum ATCC 12,472, and Pseudomonas aeruginosa PAO1. All strains were selected based on their relevance as Gram-negative pathogens with documented quorum-sensing (QS) and biofilm-forming capabilities.
Salmonella typhimurium ATCC 14,028 was selected due to its clinical relevance as a Gram-negative enteropathogen and its known ability to form robust biofilms under both environmental and host-associated conditions. Biofilm formation in S. typhimurium has been associated with increased persistence in food production systems, resistance to disinfectants, and enhanced virulence in vivo. Moreover, S. typhimurium communicates through an autoinducer-2 (AI-2)-mediated QS system that regulates motility, virulence gene expression, and biofilm development [20]. These characteristics make it a suitable model for evaluating QS inhibition and anti-biofilm activity of plant-derived extracts.
Chromobacterium violaceum ATCC 12,472 was employed as a biosensor strain for the detection of quorum-sensing inhibition through violacein pigment production, which is regulated by N-acyl homoserine lactones (AHLs). Its well-characterized QS system and ease of visual detection make it a reliable indicator for AHL-based QS inhibition.
Pseudomonas aeruginosa PAO1, a reference strain for biofilm formation and multidrug resistance, was included due to its clinical significance and its robust Las and Rhl QS systems. It serves as a standard model organism in QS research and provides a complementary assessment of QS disruption in pathogenic bacteria.
All bacterial cultures were maintained in Luria–Bertani (LB) medium at 37 °C and were subcultured regularly to ensure viability throughout the experiments.
2.3. Preparation of Aqueous Extracts
The dried plant material was ground using a stainless-steel knife mill (IKA MF 10 basic, Staufen, Germany) and sieved through a 60-mesh screen to obtain a uniform particle size of ≤250 µm, following previously described protocols [9]. Aqueous extracts were prepared by infusing 20 g of the powdered plant material in 500 mL of boiling distilled water for 30 min. The resulting infusion was cooled to room temperature, filtered through sterile gauze, frozen at −20 °C, and lyophilized for 36 h using a LABCONCO freeze dryer (Freezone 2.5, Kansas City, MO, USA). This extraction protocol was adapted from phenolic profiling methodologies previously validated in medicinal plant studies [8,9]. Final extract yields are reported in Table 1.
2.4. Antibacterial and Anti-QS Activity
To assess antibacterial and QS-inhibitory effects, a modified disk diffusion assay was performed following EUCAST guidelines [1]. Extracts were dissolved in Luria Bertani (LB) broth containing 1% dimethyl sulfoxide (DMSO) at 40 mg/mL. Sterile paper disks (6 mm) were loaded with 10 μL of extract solution and placed on LB agar plates pre-inoculated with C. violaceum. Plates were incubated at 29 °C for 26 h. Gentamicin (1 mg/mL) and 1% DMSO served as positive and negative controls, respectively. The zones of inhibition were measured in millimeters across four replicates, and results were reported as mean ± standard deviation (SD).
2.5. Violacein Quantification by Flask Incubation
The method described by Rahman et al. [2] was adapted. Briefly, tubes with 5 mL of LB broth were inoculated with 50 µL of C. violaceum and supplemented with plant extracts at concentrations of 10, 20, and 40 mg/mL. After 30 h of incubation at 30 °C, the pigment was extracted with DMSO and quantified at 585 nm. Inhibition was calculated using the following formula:
where C = OD of negative control, and T = OD of treatment.
Inhibition (%) = ((C − T)/C) × 100
2.6. Minimum Inhibitory Concentration (MIC)
Minimum inhibitory concentrations (MICs) were determined by twofold serial dilution in 24-well plates using S. typhimurium. Bacterial growth was recorded after 24 h of incubation at 37 °C following standardized antimicrobial protocols [1].
2.7. Biofilm Inhibition Assay
Using the protocol of Bazargani and Rohloff [3], biofilm inhibition was tested in 96-well microplates. Each well received 100 μL of extract (40 mg/mL) and 100 μL of S. typhimurium (1 × 106 CFU/mL), incubated at 37 °C for 8 h. Wells were washed, dried at 60 °C for 45 min, stained with 1% crystal violet, washed again, and decolorized with 96% ethanol. Absorbance at 590 nm was measured from 100 μL aliquots. Inhibition was calculated as follows:
where C = OD of negative control, and T = OD of treatment. Six replicates were analyzed.
Biofilm inhibition (%) = [1 − (T/C)] × 100
2.8. UPLC-MS Analysis of Extracts
UPLC-MS analysis was performed using an Acquity UPLC® system (Waters Corp., Milford, MA, USA), equipped with a photodiode array (PDA) detector and a Waters QDa mass detector operating in negative electrospray ionization (ESI–) mode. Chromatographic separation was carried out on a BEH C18 reverse-phase column (2.1 × 100 mm, 1.7 µm particle size) maintained at 40 °C. The mobile phase consisted of solvent A (water with 0.1% formic acid) and solvent B (acetonitrile with 0.1% formic acid), with a flow rate of 0.3 mL/min. The gradient elution program was as follows: 0–1 min, 2% B; 1–6 min, 2–15% B; 6–10 min, 15–40% B; 10–12 min, 40–95% B; 12–14 min, 95% B; and 14.1–15 min, re-equilibration at 2% B. Each run injected 20 µL of sample. Detection wavelengths were monitored between 210 and 400 nm, with primary signals at 280 and 320 nm for phenolic compounds. Compound identification was based on retention time, UV spectra, and mass spectral data, aided by the MassBank database and comparison with literature-reported phytochemical profiles [8,9].
2.9. Statistical Analysis
Statistical analyses were conducted using JASP v 0.19.3 (https://jasp-stats.org/, accessed on 26 June 2025). One-way ANOVA was employed, with significance set at p < 0.05.
3. Results
3.1. Extract Yields and Processing Efficiency
The aqueous extraction of the selected plant species yielded variable amounts of lyophilized material, reflecting differences in plant tissue composition and extractability. Tecoma stans exhibited the highest extraction yield, with 25.8% (w/w) relative to the dry weight of the starting material. This was followed by Gymnosperma glutinosum (22.6%), Ibervillea sonorae (22.1%), Olea europaea (16.7%), and Larrea tridentata (16.3%).
These variations may be attributed to differences in plant part composition (e.g., leaf vs. root or aerial tissues), moisture retention capacity, and phenolic solubility in hot water. The uniform particle size (≤250 µm) and standardized extraction conditions (boiling for 30 min, followed by lyophilization) ensured comparability across samples. Overall, these extraction yields support the feasibility of aqueous infusion as a simple yet efficient method for recovering bioactive constituents from traditionally used medicinal plants.
3.2. Anti-QS Activity in Disk Diffusion Assays
Anti-QS activity was initially evaluated using the disk diffusion method and Chromobacterium violaceum as the reporter strain. Extracts of Gymnosperma glutinosum, Tecoma stans, Larrea tridentata, and Olea europaea produced zones of violacein inhibition, visible as fading or absence of the characteristic purple pigment. In contrast, Ibervillea sonorae exhibited no QS or antimicrobial effect under these conditions.
Figure 1 shows that G. glutinosum and T. stans displayed the strongest QS inhibition at 40 mg/mL, with 60.02% and 52.72% violacein reduction, respectively.

Figure 1.
Inhibition of violacein production by aqueous extracts of Gymnosperma glutinosum and Tecoma stans at different concentrations (10, 20, and 40 mg/mL). G. glutinosum showed the highest violacein inhibition (60.02%) at 40 mg/mL, followed by T. stans (52.72%). Error bars represent standard deviation (n = 5).
3.3. Violacein Quantification (Flask Assay)
Quantitative assessment via flask incubation confirmed a concentration-dependent trend in violacein inhibition. Although statistical significance was not reached (p > 0.05), a clear linear relationship was observed for both G. glutinosum and T. stans, with the former showing the highest effect at 40 mg/mL (Figure 2).
Figure 2.
Disk diffusion assay showing quorum-sensing inhibition on Chromobacterium violaceum. The plate illustrates zones of pigment inhibition or discoloration around plant extracts at 40 mg/mL. The positive control (gentamicin, 10 µg/disk) displayed a well-defined halo, indicating both antimicrobial and anti-QS activity. Gymnosperma glutinosum and Tecoma stans produced pigment disruption halos suggestive of quorum-sensing inhibition. Ibervillea sonorae showed no inhibition. Larrea tridentata and Olea europaea exhibited antimicrobial halos. The negative control (1% DMSO) showed no inhibition.
3.4. Antibacterial Activity and Minimum Inhibitory Concentration
Table 2 summarizes the antibacterial activity and MIC values of the tested plant extracts, along with the inhibition zone of the positive control, gentamicin (10 µg/disc). Only L. tridentata and O. europaea showed measurable antimicrobial zones (~10 mm), while G. glutinosum exhibited an MIC of 6.8 mg/mL despite showing no inhibition halo, suggesting a potential intracellular or delayed activity. I. sonorae and T. stans also failed to produce visible inhibition zones, indicating that their antibacterial mechanisms may be non-bactericidal, such as quorum-sensing inhibition. All data represent the mean ± SD from five independent replicates.

Table 2.
Inhibition zone diameters and minimum inhibitory concentration (MIC) values of aqueous plant extracts (mean ± SD, n = 5).
Taken together, these findings suggest a dose-dependent inhibitory effect, where extracts with lower MIC values displayed stronger antimicrobial activity, even in the absence of visible inhibition zones, reinforcing the relevance of evaluating both solid and liquid media responses to capture the full spectrum of antimicrobial potential.
Ibervillea sonorae showed moderate activity, with an MIC of 9.8 ± 0.45 mg/mL, despite the absence of measurable inhibition zones. In contrast, Tecoma stans did not display any inhibitory zones or significant MIC values at concentrations below 40 mg/mL, suggesting that its biological activity is not primarily bactericidal but may instead act through the disruption of bacterial communication via quorum-sensing (QS) mechanisms.
These findings emphasize the differential modes of action among the tested plant extracts and support further exploration of their quorum-sensing and anti-biofilm potentials, particularly in the case of T. stans and G. glutinosum.
3.5. Biofilm Inhibition (Initial Cell Attachment)
Despite lacking QS or antimicrobial activity, I. sonorae exhibited exceptional antibiofilm effects, reducing initial cell adhesion by 88.88% (Figure 3). All extracts surpassed the 50% inhibition threshold at 40 mg/mL, with G. glutinosum showing the lowest effect (62.26%).

Figure 3.
Inhibition of initial biofilm formation by aqueous plant extracts at 40 mg/mL. Ibervillea sonorae exhibited the highest inhibition (89.88%), followed by Tecoma stans (72.13%), Olea europaea (71.14%), and Gymnosperma glutinosum (62.26%). Error bars represent standard deviation (n = 6).
Statistical analysis revealed a significant difference (p < 0.05) between I. sonorae and G. glutinosum, but not among the other extracts.
3.6. UPLC-MS Phytochemical Profiling
Ultra-performance liquid chromatography coupled with mass spectrometry (UPLC-MS) analysis was conducted to characterize major phytochemicals present in the most active aqueous extracts. The chemical profiles of Tecoma stans and Gymnosperma glutinosum revealed distinct yet bioactive compound signatures. (Figure 4).

Figure 4.
UPLC-MS chromatographic profiles of aqueous extracts from the most active plant species. (A) Tecoma stans extract showing three major compounds: 1—D-(−)-Quinic acid; 2—Glucuronic acid; 3—Kaempferol. (B) Gymnosperma glutinosum extract: 1—Chlorogenic acid; 2—Kaempferol; 3—Chlorogenic acid isomer. Additional peaks between 3 and 6 min suggest unidentified phenolic or flavonoid-like compounds.
In Tecoma stans, three major peaks were observed within the early retention range (0–1 min), all consistent with small polar metabolites (Table 3).

Table 3.
Identified peaks in the UPLC-MS profile of Tecoma stans aqueous extract.
In Gymnosperma glutinosum, major peaks appeared in the intermediate retention range (3–5 min), associated with phenolic acids and flavonoids (Table 4).

Table 4.
Identified peaks in the UPLC-MS profile of Gymnosperma glutinosum aqueous extract.
Beyond these three peaks per extract, both chromatograms revealed multiple additional signals between 3–6 min, suggesting the presence of uncharacterized phenolic acids, flavonoid glycosides, or other hydrophilic secondary metabolites [9].
The identification of kaempferol and chlorogenic acid is particularly relevant, as both compounds have been extensively documented as quorum-sensing inhibitors in Gram-negative bacteria. Chlorogenic acid, in particular, has been shown to downregulate QS-regulated virulence genes and biofilm formation in Pseudomonas aeruginosa [9,18].
These findings indicate that the observed biological activities, such as violacein inhibition and disruption of biofilm formation, are likely mediated by synergistic interactions among multiple compounds rather than a single active principle.
4. Discussion
This study provides a comprehensive assessment of five medicinal plant species native to northeastern Mexico—Gymnosperma glutinosum, Ibervillea sonorae, Larrea tridentata, Olea europaea, and Tecoma stans—with an emphasis on their ability to interfere with bacterial quorum-sensing (QS) systems and biofilm formation. Our approach integrated antimicrobial screening, QS inhibition bioassays, violacein quantification, biofilm inhibition measurements, and phytochemical profiling by UPLC-MS.
In the disk diffusion assays, G. glutinosum and T. stans exhibited visible pigment inhibition halos against Chromobacterium violaceum, indicative of potential QS interference, while L. tridentata and O. europaea showed antimicrobial halos consistent with bacterial growth inhibition. Interestingly, I. sonorae did not produce any inhibition zone under the same conditions, possibly due to the lower diffusion of active compounds or insufficient concentrations at the site of interaction.
The violacein inhibition assay provided quantitative evidence of QS disruption. G. glutinosum achieved 60.02% inhibition at 40 mg/mL, followed by T. stans and O. europaea, which also showed moderate reductions. These results align with prior findings that plant-derived compounds can effectively attenuate QS-regulated pigment production in C. violaceum and related bacteria [6,19].
Unexpectedly, I. sonorae, which lacked QS and antimicrobial activity, achieved the highest biofilm inhibition (89.89%), suggesting the presence of non-QS-dependent antibiofilm metabolites. These could target early adhesion or extracellular matrix production, a hypothesis supported by transcriptomic studies showing distinct regulatory pathways for biofilm formation and QS [20]. The other species, including G. glutinosum, T. stans, and O. europaea, exhibited moderate biofilm inhibition levels around 62–72%, corroborating their broad-spectrum bioactivity [21,22].
Phytochemical analysis using UPLC-MS identified bioactive constituents linked to the observed effects. T. stans extracts contained D-(−)-quinic acid, glucuronic acid, and kaempferol, while G. glutinosum exhibited chlorogenic acid and kaempferol as prominent peaks. These phenolics and flavonoids have been previously implicated in QS inhibition [21,23,24]. Chlorogenic acid, in particular, interferes with Pseudomonas aeruginosa virulence via the las and rhl systems, reducing motility and biofilm formation [24]. Kaempferol and its glycosides have shown in silico binding affinity for QS-related regulatory proteins [25,26]. The presence of these compounds in our extracts supports their contribution to the bioactivities observed.
However, UPLC-MS has limitations in detecting highly polar metabolites, glycosides, and minor components due to ionization inefficiencies or co-elution effects. Thus, the biological activity may involve synergistic effects of undetected compounds acting through multifactorial mechanisms such as membrane perturbation, oxidative stress induction, or signal antagonism [27,28,29]. These multi-target interactions are typical of plant extracts and reduce the risk of resistance development, an advantage over traditional antibiotics [30,31].
The findings underscore the therapeutic potential of traditional Mexican flora as sources of anti-QS and antibiofilm agents. They also validate ethnobotanical knowledge that guided plant selection, particularly for G. glutinosum and T. stans, which demonstrated consistent and multifaceted activity. Moreover, the high biofilm inhibition by I. sonorae opens new avenues to investigate non-QS mechanisms of biofilm control [32,33].
Considering global antimicrobial resistance concerns, the identification of plant-based QS modulators offers a promising complementary strategy to disarm pathogens without applying lethal selective pressure. Future work should pursue bioassay-guided fractionation, metabolomics, and in vivo validation to identify and characterize the active principles, their targets, and their pharmacodynamics [34].
5. Conclusions
This study evaluated the quorum-sensing (QS) inhibitory and antibiofilm potential of five aqueous plant extracts from northeastern Mexico. Among them, Gymnosperma glutinosum and Tecoma stans significantly reduced violacein production in Chromobacterium violaceum, while Ibervillea sonorae showed notable biofilm inhibition despite lacking QS or antimicrobial activity. Larrea tridentata and Olea europaea displayed antibacterial effects. These results highlight the multi-targeted actions of native plant metabolites and support their potential use as non-bactericidal alternatives for controlling bacterial pathogenicity. Further investigations are warranted to isolate active compounds and explore their mechanisms of action.
Author Contributions
U.C.-V. and V.E.A.-A. conceived the study and designed and supervised the experiments. O.P.-G., V.E.A.-A. and J.E.Q.-H. worked with the bacterial assays. G.H.-V. acquired the samples. O.P.-G., V.E.A.-A., J.E.Q.-H. and U.C.-V. contributed to assays and statistical results analysis. O.P.-G., V.E.A.-A., U.C.-V. and G.H.-V. contributed to writing—review and editing. All authors have read and agreed to the published version of the manuscript.
Funding
This research was conducted with the support of the PROACTI initiative from the Universidad Autónoma de Nuevo León (UANL) under grant number 74-CAAFE-2024.
Data Availability Statement
The data supporting the findings of this study are available from the corresponding author upon reasonable request.
Acknowledgments
The authors thank the Faculty of Biological Sciences (UANL) for providing herbarium access and technical assistance. We also acknowledge the support from the Sistema Nacional de Investigadoras e Investigadores (SNII) of SECIHTI (Mexico) through researcher registry numbers 73211 (O.P.-G.) and 49531 (V.E.A.-A.), which recognize their contributions to national scientific development.).
Conflicts of Interest
The authors have declared that there are no conflicts of interest.
References
- European Committee on Antimicrobial Susceptibility Testing. Antimicrobial Susceptibility Testing EUCAST Disk Diffusion Method. 2017. Available online: https://www.eucast.org (accessed on 1 January 2021).
- Rahman, M.R.T.; Lou, Z.; Yu, F.; Wang, P.; Wang, H. Anti-quorum sensing and anti-biofilm activity of Amomum tsaoko on foodborne pathogens. Saudi J. Biol. Sci. 2017, 24, 324–330. [Google Scholar] [CrossRef] [PubMed]
- Bazargani, M.M.; Rohloff, J. Antibiofilm activity of essential oils and plant extracts against Staphylococcus aureus and Escherichia coli biofilms. Food Control. 2016, 61, 156–164. [Google Scholar] [CrossRef]
- Ramírez, G.; Zamilpa, A.; Zavala, M.; Pérez, J.; Morales, D.; Tortoriello, J. Chrysoeriol and other polyphenols from Tecoma stans with lipase inhibitory activity. J. Ethnopharmacol. 2016, 185, 1–8. [Google Scholar] [CrossRef]
- Gómez-Flores, R.; Espinosa-Ramos, D.; Quintanilla-Licea, R.; Barrón-González, M.P.; Tamez-Guerra, P.; Tamez-Guerra, R.; Rodríguez-Padilla, C. Antimicrobial activity of Gymnosperma glutinosum methanol extracts against Helicobacter pylori. Afr. J. Tradit. Complement. Altern. Med. 2016, 13, 55–59. [Google Scholar] [CrossRef][Green Version]
- Nazzaro, F.; Fratianni, F.; Coppola, R. Quorum sensing and phytochemicals. Int. J. Mol. Sci. 2013, 14, 12607–12619. [Google Scholar] [CrossRef]
- Favela-Hernández, J.M.J.; García, A.; Garza-González, E.; Rivas-Galindo, V.M.; Camacho-Corona, M.R. Antibacterial and antimycobacterial lignans and flavonoids from Larrea tridentata. Phytother. Res. 2012, 26, 1957–1960. [Google Scholar] [CrossRef]
- Pereira, A.P.; Ferreira, I.C.; Marcelino, F.; Valentão, P.; Andrade, P.B.; Seabra, R.; Estevinho, L.; Bento, A.; Pereira, J.A. Phenolic compounds and antimicrobial activity of olive (Olea europaea) leaves. Molecules 2007, 12, 1153–1163. [Google Scholar] [CrossRef]
- Castro-López, C.; Bautista-Hernández, I.; González-Hernández, M.D.; Martínez-Ávila, G.C.G.; Rojas, R.; Gutiérrez-Díez, A.; Medina-Herrera, N.; Aguirre-Arzola, V.E. Polyphenolic Profile and Antioxidant Activity of Leaf Purified Hydroalcoholic Extracts from Seven Mexican Persea americana Cultivars. Molecules 2019, 24, 173. [Google Scholar] [CrossRef]
- Gómez-Flores, R.; Quintanilla-Licea, R.; Verde-Star, M.J.; Morado-Castillo, R.; Vázquez-Díaz, D.; Tamez-Guerra, R.; Tamez-Guerra, P.; Rodríguez-Padilla, C. Long-chain alkanes and ent-labdane-type diterpenes from G. glutinosum with cytotoxic activity. Phytother. Res. 2012, 26, 1632–1636. [Google Scholar] [CrossRef]
- Delgadillo-Ruíz, L.; Bañuelos-Valenzuela, R.; Delgadillo-Ruíz, O.; Silva-Vega, M.; Gallegos-Flores, P. Composición química y efecto antibacteriano de extractos de L. tridentata. Nova Sci. 2017, 9, 273–290. [Google Scholar] [CrossRef]
- Lira-Saldivar, F.D.; Hernández-Suárez, R.H.; Hernández-Castillo, M. Activity of L. tridentata and chitosan against fungi. Rev. Chapingo Ser. Hortic. 2006, 12, 211–216. [Google Scholar] [CrossRef]
- Morado-Castillo, R.; Quintanilla-Licea, R.; Gómez-Flores, R.; Blaschek, W. Total phenolic and flavonoid contents of G. glutinosum. Eur. J. Med. Plants 2016, 15, 1–8. [Google Scholar] [CrossRef]
- González-Chávez, M.M.; Arana-Argaéz, V.; Zapata-Morales, J.R.; Avila-Venegas, A.K.; Alonso-Castro, A.J.; Isiordia-Espinoza, M.; Martínez, R. Pharmacological evaluation of 2-angeloyl ent-dihydrotucumanoic acid. Pharm. Biol. 2017, 55, 873–879. [Google Scholar] [CrossRef]
- Alonso-Castro, A.J.; González-Chávez, M.M.; Zapata-Morales, J.R.; Verdinez-Portales, A.K.; Sánchez-Recillas, A.; Ortiz-Andrade, R.; Isiordia-Espinoza, M.; Martínez-Gutiérrez, F.; Ramírez-Morales, M.A.; Domínguez, F.; et al. Antinociceptive activity of ent-dihydrotucumanoic acid isolated from G. glutinosum. Drug Dev. Res. 2017, 78, 340–348. [Google Scholar] [CrossRef]
- Salazar-Aranda, R.; Perez-Lopez, L.A.; Lopez-Arroyo, J.; Alanis-Garza, B.A.; Waksman de Torres, N. Antimicrobial and antioxidant activities of plants from northeast Mexico. Evid. Based Complement. Alternat. Med. 2011, 2011, 536139. [Google Scholar] [CrossRef]
- Bashyal, B.; Li, L.; Bains, T.; Debnath, A.; LaBarbera, D.V. L. tridentata: A novel source for anti-parasitic agents. PLoS Negl. Trop. Dis. 2017, 11, e0005832. [Google Scholar] [CrossRef]
- Papenfort, K.; Bassler, B.L. Quorum sensing signal–response systems in Gram-negative bacteria. Nat. Rev. Microbiol. 2016, 14, 576–588. [Google Scholar] [CrossRef]
- Damte, D. Evaluation of anti-quorum sensing activity of 97 indigenous plant extracts. J. Microb. Biochem. Technol. 2013, 5, 42–46. [Google Scholar] [CrossRef]
- Abudoleh, S.M.; Mahasneh, A.M. Anti-quorum sensing activity of substances from wild berry–associated bacteria. Avicenna J. Med. Biotechnol. 2017, 9, 23–30. [Google Scholar]
- Jesudhasan, P.R.; Cepeda, M.L.; Widmer, K.; Dowd, S.E.; Soni, K.A.; Hume, M.E.; Zhu, J.; Pillai, S.D. Transcriptome analysis of genes regulated by luxS/autoinducer-2 in Salmonella enterica serovar Typhimurium. Foodborne Pathog. Dis. 2010, 7, 399–410. [Google Scholar] [CrossRef]
- Rammo, R.N.N. Bactericidal and anti-biofilm formation of aqueous plant extracts against pathogenic bacteria. Asian J. Pharm. Res. 2017, 7, 25–29. [Google Scholar] [CrossRef]
- Ilk, S.; Saglam, N.; Ozgen, M.; Korkusuz, F. Chitosan nanoparticles enhance the anti-quorum sensing activity of kaempferol. Int. J. Biol. Macromol. 2017, 94, 653–662. [Google Scholar] [CrossRef]
- Liang, L.; Sproule, A.; Haltli, B.; Marchbank, D.H.; Berrué, F.; Overy, D.P.; McQuillan, K.; Lanteigne, M.; Duncan, N.; Correa, H.; et al. A new natural product and quorum sensing deactivation by culturing with heat-killed inducer. Front. Microbiol. 2019, 9, 3351. [Google Scholar] [CrossRef]
- Xu, W.; Zhang, X.; Wang, L.; Zeng, W.; Sun, Y.; Zhou, C.; Zhou, T.; Shen, M. Effect of chlorogenic acid on the quorum-sensing system of clinically isolated multidrug-resistant Pseudomonas aeruginosa. J. Appl. Microbiol. 2022, 132, 1008–1017. [Google Scholar] [CrossRef]
- Majumdar, G.; Mandal, S. Antibacterial activity analysis of kaempferol and its derivatives targeting virulence and quorum sensing associated proteins by in silico methods. Microbe 2025, 6, 100259. [Google Scholar] [CrossRef]
- Wang, H.; Liu, Y.; Gao, D.; Zang, Y.; Zhang, X.; Bao, G. Chlorogenic acid inhibits quorum sensing-controlled virulence factors and biofilm formation in Pseudomonas aeruginosa. Appl. Microbiol. Biotechnol. 2019, 103, 9039–9051. [Google Scholar] [CrossRef]
- Vega-Menchaca, M.C.; Morales, C.R.; Star, J.V.; Or, A.; Morales, M.E.R.; Nuntilde, M.A.; Gallardo, L.B.S. Antimicrobial activity of five plants from Northern Mexico. Afr. J. Microbiol. Res. 2013, 7, 5011–5017. [Google Scholar] [CrossRef]
- Pires, F.B.; Dolwitsch, C.B.; Prá, V.D.; Faccin, H.; Monego, D.L.; de Carvalho, L.M.; Viana, C.; Lameira, O.; Lima, F.O.; Bressan, L.; et al. Qualitative and quantitative analysis of phenolic content by HPLC-DAD and UHPLC-ESI-MS/MS. Rev. Bras. Farmacogn. 2017, 27, 426–433. [Google Scholar] [CrossRef]
- Pires, F.B.; Dolwitsch, C.B.; Prá, V.D.; Faccin, H.; Monego, D.L.; de Carvalho, L.M.; Viana, C.; Lameira, O.; Lima, F.O.; Bressan, L.; et al. Polyphenol–protein complexes in biofilm prevention. Sci. Total Environ. 2019, 658, 1098–1105. [Google Scholar] [CrossRef]
- Bin Zaman, S.; Hussain, M.A.; Nye, R.; Mehta, V.; Mamun, K.T.; Hossain, N. A review on antibiotic resistance: Alarm bells are ringing. Cureus 2017, 9, e1403. [Google Scholar] [CrossRef]
- Willyard, C. Drug-resistant bacteria ranked. Nature 2017, 543, 15. [Google Scholar] [CrossRef] [PubMed]
- Hung, C.-M.; Chang, C.-C.; Lin, C.-W.; Ko, S.-Y.; Hsu, Y.-C. Cucurbitacin E as inducer of apoptosis in oral cancer. Int. J. Mol. Sci. 2013, 14, 17147–17156. [Google Scholar] [CrossRef] [PubMed]
- Hamed, M.M.; Mohamed, M.A.; Ibrahim, M.T. Cytotoxic activity of secondary metabolites from Tecomaria capensis. Int. J. Pharm. Phytochem. Res. 2016, 8, 1173–1182. [Google Scholar]
Disclaimer/Publisher’s Note: The statements, opinions and data contained in all publications are solely those of the individual author(s) and contributor(s) and not of MDPI and/or the editor(s). MDPI and/or the editor(s) disclaim responsibility for any injury to people or property resulting from any ideas, methods, instructions or products referred to in the content. |
© 2025 by the authors. Licensee MDPI, Basel, Switzerland. This article is an open access article distributed under the terms and conditions of the Creative Commons Attribution (CC BY) license (https://creativecommons.org/licenses/by/4.0/).